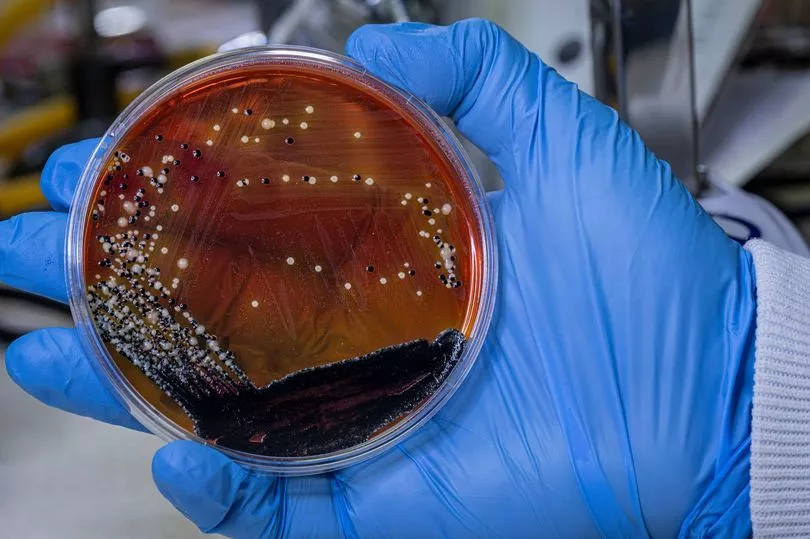

Bowel
Understand the causes, symptoms, and treatment options for bowel cancer. Stay informed on the latest research, early detection methods, and ways to improve patient outcomes.

Eight ways to reduce your risk of bowel cancer
Around half of all bowel cancers could be prevented by having a healthier lifestyle
Bowel Cancer Breakthrough: Bacteria That Causes Grim Infection Could Be Key to New Treatments
Scientists have discovered that a specific bacterium associated with severe infections may hold the key to developing new treatments for bowel cancer.

Peptide-Coated Nanoparticles Enhance Drug Delivery for Cancer Treatment
A new study reveals that peptide-coated nanoparticles can improve the delivery and efficacy of cancer drugs, potentially reducing side effects.

Bowel cancer breakthrough as bacteria that causes grim infection could be key to new treatments
cientists are suggesting that Salmonella bacteria could be harnessed to combat cancer. UK researchers are investigating the potential for these bacteria to inhibit tumour cell proliferation in bowel cancer cases.

Glass of milk a day cuts bowel cancer risk – study – BBC News
Dark leafy greens, bread and non-dairy milks containing calcium were also found to offer protection.

Protein CD74 can predict immunotherapy response in bowel cancer, independent of subtype
Bowel cancer is the fourth most common cancer in the UK, and the second most common cause of cancer death. The disease falls into two types: one where proteins that repair errors in DNA are missing or deficient (the deficient subtype), and one where this machinery is intact (the proficient subtype).

Five unexpected ways to reduce your risk of bowel cancer
Habits from a daily glass of milk to flossing can protect against the second biggest cancer killer in the UK